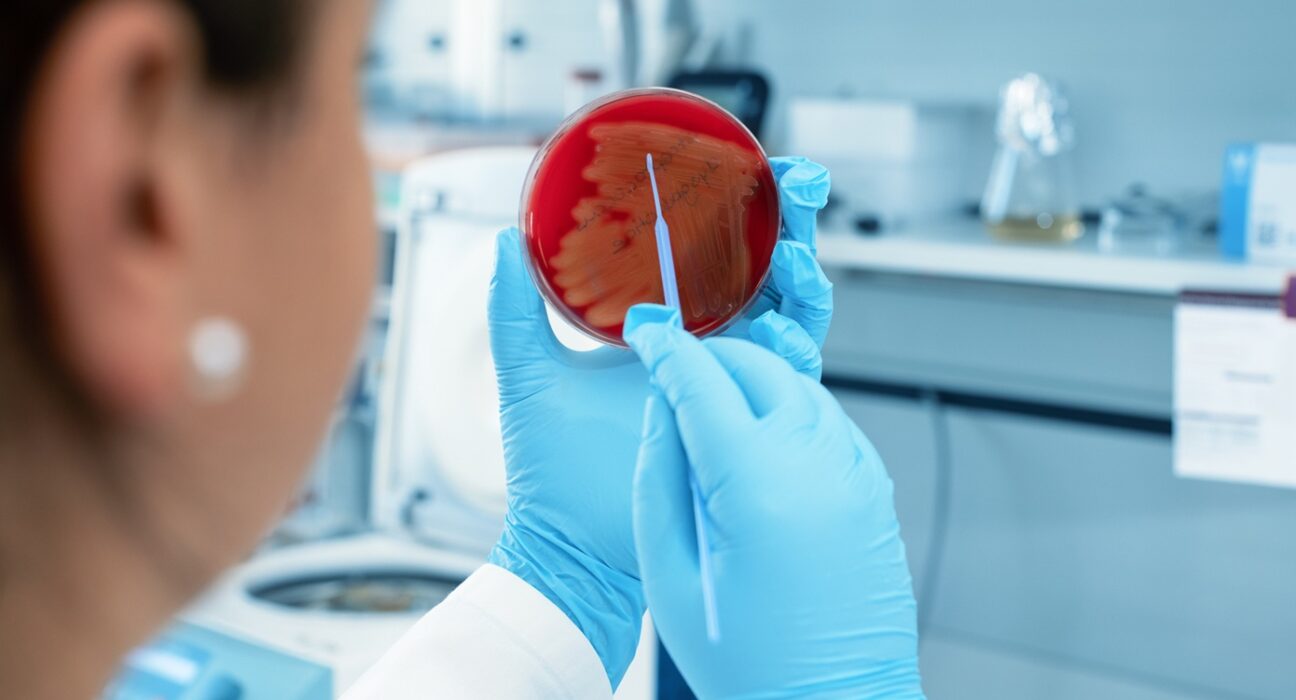

Ιατρικός Σύλλογος Αθηνών – ΕΚΠΑ: Στο επίκεντρο η εκπαίδευση των ιατρών για τη συνετή διαχείριση των αντιβιοτικών
Με επίκεντρο ένα από τα σοβαρότερα προβλήματα δημόσιας υγείας, τη μικροβιακή αντοχή, πραγματοποιήθηκε με μεγάλη συμμετοχή το δεύτερο Μετεκπαιδευτικό Σεμινάριο του Ιατρικού Συλλόγου Αθηνών (ΙΣΑ) με θέμα «Η ορθολογική διαχείριση των αντιβιοτικών στο νοσοκομείο». Το σεμινάριο, υπό την αιγίδα του ΕΚΠΑ και της Ελληνικής Εταιρείας Χημειοθεραπείας, απευθύνθηκε σε νοσοκομειακούς παθολόγους και αιματολόγους/ογκολόγους, αναδεικνύοντας τη σημασία της συνεχιζόμενης εκπαίδευσης των ιατρών για τη συνετή χρήση των αντιβιοτικών, σε μια χώρα που εξακολουθεί να καταγράφει από τα υψηλότερα ποσοστά μικροβιακής αντοχής στην Ευρώπη. Η εκπαίδευση των νοσοκομειακών ιατρών αποτελεί κρίσιμο παράγοντα για τον περιορισμό της αντοχής και την ενίσχυση της ασφάλειας των ασθενών. Σημειώνεται ότι ο ΙΣΑ διοργανώνει μια ολοκληρωμένη σειρά διαδραστικών μετεκπαιδευτικών σεμιναρίων που ξεκίνησαν τον Νοέμβριο και θα διαρκέσουν έως το καλοκαίρι 2026 και περιλαμβάνουν διαλέξεις, συζητήσεις περιστατικών, εργαστήρια σε μικρές ομάδες, χρήση τοπικών αντιβιογραμμάτων, προσομοιώσεις και εργαλεία αντιβιοτικής επιτήρησης. Μάλιστα έχουν αξιοποιηθεί τα νέα τεχνικά εργαλεία προκειμένου να είναι διαδραστικά με ενεργή συμμετοχή των ιατρών μέσω εφαρμογής στο κινητό. […] Με επίκεντρο ένα από τα σοβαρότερα προβλήματα δημόσιας υγείας, τη μικροβιακή αντοχή, πραγματοποιήθηκε με μεγάλη συμμετοχή το δεύτερο Μετεκπαιδευτικό Σεμινάριο του Ιατρικού Συλλόγου Αθηνών (ΙΣΑ) με θέμα «Η ορθολογική διαχείριση των αντιβιοτικών στο νοσοκομείο». Το σεμινάριο, υπό την αιγίδα του ΕΚΠΑ και της Ελληνικής Εταιρείας Χημειοθεραπείας, απευθύνθηκε σε νοσοκομειακούς παθολόγους και αιματολόγους/ογκολόγους, αναδεικνύοντας τη σημασία της συνεχιζόμενης εκπαίδευσης των ιατρών για τη συνετή χρήση των αντιβιοτικών, σε μια χώρα που εξακολουθεί να καταγράφει από τα υψηλότερα ποσοστά μικροβιακής αντοχής στην Ευρώπη. Η εκπαίδευση των νοσοκομειακών ιατρών αποτελεί κρίσιμο παράγοντα για τον περιορισμό της αντοχής και την ενίσχυση της ασφάλειας των ασθενών. Σημειώνεται ότι ο ΙΣΑ διοργανώνει μια ολοκληρωμένη σειρά διαδραστικών μετεκπαιδευτικών σεμιναρίων που ξεκίνησαν τον Νοέμβριο και θα διαρκέσουν έως το καλοκαίρι 2026 και περιλαμβάνουν διαλέξεις, συζητήσεις περιστατικών, εργαστήρια σε μικρές ομάδες, χρήση τοπικών αντιβιογραμμάτων, προσομοιώσεις και εργαλεία αντιβιοτικής επιτήρησης. Μάλιστα έχουν αξιοποιηθεί τα νέα τεχνικά εργαλεία προκειμένου να είναι διαδραστικά με ενεργή συμμετοχή των ιατρών μέσω εφαρμογής στο κινητό. ΕΛΛΑΔΑ, ιατρικός σύλλογος Αθηνών


